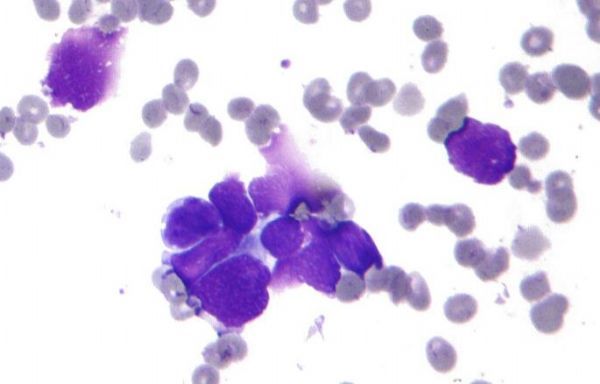

解读外泌体领域的重要研究成果!
外泌体是一种直径在40-100nm的盘状囊泡,多种细胞在正常及病理状态下均可分泌外泌体。1980年科学家们首次发现外泌体,此前外泌体被认为是细胞排泄废物的一种方式,如今随着科学家们研究的深入,他们发现外泌体具有多种多样的功能。本文中,小编就对外泌体领域的相关研究进展进行整理,分享给大家!(外泌体提取)
【1】Nature:重磅!揭示癌细胞抑制抗肿瘤免疫反应新机制-从远处释放携带PD-L1的外泌体
doi:10.1038/s41586-018-0392-8
癌细胞并不仅仅是一群生长失去控制的细胞;为了自身的生存,它们积极地参与与免疫系统之间的斗争。能够逃避免疫系统检测是癌症的一种特征。在一项新的研究中,来自美国宾夕法尼亚大学的研究人员发现癌细胞释放生物“无人机”---在血液中循环的被称作外泌体(exosome)的小囊泡,这些小囊泡携带着PD-L1蛋白,这种蛋白导致T细胞在到达肿瘤并进行战斗之前精疲力竭---来协助这种斗争。尽管这项研究主要针对转移性黑色素瘤,但是这些研究人员发现乳腺癌和肺癌也会释放携带着PD-L1的外泌体。相关研究结果于2018年8月8日在线发表在Nature期刊上。
这项研究以一种颠覆现有观念的方式展示了癌症如何采取一种系统性方法来抑制免疫系统。此外,它还指出了一种新方法来预测哪些癌症患者会对通过破坏免疫抑制来抵抗肿瘤的抗PD1疗法(anti-PD1 therapy)作出反应,并提供一种追踪这类疗法治疗效果的方法。
Guo说,“对许多转移性黑色素瘤患者来说,免疫疗法可以挽救生命,但是大约70%的这些患者没有作出反应。这类疗法费用昂贵并且具有毒副作用,因此了解哪些患者会作出反应将是有帮助的。鉴定血液中的生物标志物可能有助于及早预测哪些患者会作出反应,以及随后可能为患者及其医生提供一种监测治疗效果的方法。”
【2】Cancer Res:巨噬细胞分泌外泌体促进胰腺癌抵抗吉西他滨
doi:10.1158/0008-5472.CAN-18-0124
吉西他滨通过终止DNA复制来抑制细胞生长的一种抗肿瘤药物,临床上用作晚期胰腺癌患者在氟尿嘧啶类失败后的二线用药,能够改善患者的生活质量,但胰腺导管腺癌会对吉西他滨产生抵抗。肿瘤相关巨噬细胞最近被证明能够促进癌细胞对吉西他滨的抵抗,但是这一过程的确切机制还不明确。
最近来自以色列Rambam医学中心的研究人员对胰腺导管腺癌抵抗抗肿瘤药物吉西他滨的机制进行了深入研究,并将相关研究结果发表在国际学术期刊Cancer Research上。
在这项研究中,研究人员通过一个胰腺导管腺癌的基因小鼠模型和电镜分析,发现肿瘤相关巨噬细胞通过分泌外泌体与肿瘤微环境交流,并且这些外泌体能够被癌细胞特异性捕获内化。研究人员将合成的dsDNA转入小鼠腹膜巨噬细胞中,再将细胞注射到胰腺导管腺癌荷瘤小鼠体内,发现原位肿瘤和肝转移灶内的dsDNA片段浓度比正常组织中更高。
【3】甲状腺癌干细胞样外泌体通过转移lncRNA调节EMT
甲状腺癌是最常见的内分泌恶性肿瘤,其中约2%的甲状腺癌是甲状腺未分化癌(anaplastic thyroid carcinoma, ATC),是最致命和具治疗抗性的人类癌症之一。肿瘤干细胞样细胞(CSC)可以引发肿瘤发生,诱导对化学疗法和放射疗法的抗性,具有多种促肿瘤能力并且可能导致复发和转移。
CSC的产生与上皮间质转化(EMT)和干性的获得有关。外泌体是由大多数细胞分泌的小(30-150nm)膜囊泡,其在细胞间通信中起重要作用。许多非编码RNA(ncRNA),例如长链非编码RNA(lncRNA),可以启动肿瘤发生和EMT过程,而外泌体可以携带ncRNA到局部和远端细胞。
本研究从两种体外培养的细胞(EMT模型细胞和CSC模型细胞)中检测分泌的外泌体。通过TGFβ-1处理在甲状腺乳头状癌(PTC)细胞系中诱导EMT。分离来自该细胞模型的外泌体并与初始PTC细胞共培养并检测EMT诱导情况。在CSC模型中,从CSC细胞系中分离外泌体,与正常甲状腺细胞系一起培养并检测EMT诱导。 EMT外泌体能够转移lncRNA MALAT1和EMT效应因子SLUG和SOX2。
【4】Analy Chem:科学家开发出一种外泌体定量新方法
doi:10.1021/acs.analchem.8b00189
近日,一篇刊登在Analytical Chemistry杂志上文章中,来自浙江大学附属第二医院/转化医学研究院的科学家们报道了一种外泌体定量的新方法。外泌体是细胞分泌的具有磷脂双分子层的纳米囊泡,其膜性质与细胞膜类似。基于这一性质,我们利用细胞表面工程技术对外泌体膜进行了有目的的修饰。
目前流行的数字PCR技术是用来定量检测核酸的一种技术,其基本原理是将有限的DNA分子随机分配到大量小室中,在小室多于DNA分子的情况下,每个小室中的核酸分子多于一个DNA分子的概率非常低,然后对众多小室中的DNA进行扩增,结果是带有DNA分子的小室会呈现阳性信号,而没有DNA分子的小室呈现阴性信号。最后通过计数小室中阳性孔的量来计数原始的DNA浓度。
这篇文章中,我们将此数字检测的原理用于外泌体检测。外泌体是处于30-150 纳米左右的纳米颗粒,其在液体溶液中具有很好的分散性,在芯片中也像核酸分子一样随机分配,因此可以利用数字检测的方法来对外泌体进行定量。
【5】Hepatology:鉴定血清外泌体中与胆管癌相关的蛋白生物标志物
胆管癌(CCA)是恶性度较高的消化系统肿瘤。因其发展隐蔽且临床症状及体征出现晚,故给早期诊断带来困难。原发性硬化性胆管炎(PSC)是导致胆管癌的主要原因之一。在非侵染时期,鉴定肝内的胆管癌及肝癌(HCC)是非常困难的。目前尚未有准确区分CCA,PSC,及HCC的生物标记物。
为了寻找新的生物标志物,来自西班牙的研究者,利用高效的外泌体分离方法,分别从CCA、PSC,和HCC患者的血清样本中分离得到外泌体,运用蛋白质组学技术从中筛选出新的生物标记物,具有作为临床诊断工具的潜在应用价值,研究结果发表在国际著名期刊Hepatology上。
【6】Nat Rev Neurol:外泌体可以传播毒性淀粉样蛋白导致阿尔茨海默病
根据Acta Neuropathologica(IF 12.213)发表的一项新研究,外泌体可以介导阿尔茨海默病(AD)毒性淀粉样蛋白-β(Aβ)的细胞间的病理传播。此外,研究人员能够阻止这种外泌体介导的传播,这表明该机制是阿尔茨海默病中的新型治疗靶点。
先前的研究已经证明Aβ可以以朊病毒样的方式从一个细胞传播到另一个细胞。然而,Aβ在细胞间转移的机制尚不清楚。在他们的新研究中,Martin Hallbeck及其同事研究了外泌体在转移毒性淀粉样蛋白-β寡聚体(oAβ)中是否有作用。
“外泌体由胞内体而形成,我们从早期的研究中得知,Aβ的细胞内毒性聚集体通常在胞内体中结束,”Hallbeck解释说。 “从这个角度来看,我们推测这些聚集体可能以外泌体的形式出现,从而传播到下一个细胞。”
【7】Science子刊:科学家开发出新型外泌体高效修饰方法将大力促进外泌体的诊断与治疗应用
外泌体可以用于递送治疗性药物或修饰基因表达,但是当全身给予时,难以靶向特定的组织。来自天津医科大学的尹海芳教授团队近日在Science Translational Medicine发表文章,开发了一种肽CP05,它与外泌体上表达的蛋白CD63结合。用CP05偶联到肌肉靶向肽上修饰外泌体增加了剪接矫正寡聚体向肌肉的递送,可增加肌营养不良小鼠模型中的肌养蛋白的表达和肌肉功能。利用CP05也可以从人血清中分离外泌体。这项研究表明,CP05可用于捕获和修饰外泌体及其货物以进行靶向递送。
外泌体是大小为30-150 nm(直径)的纳米级囊泡,由大多数哺乳动物细胞分泌,并携带来自其亲本细胞的许多大分子。这些独特的特征使外泌体可以用作妊娠和各种恶性肿瘤的诊断标记物,并且还用作抗癌化学治疗剂、核酸等各种货物的递送载体。为了避免触发免疫反应,理想的治疗性外泌体应该是患者来源的,并且随后的修饰不应当实质上影响外泌体的结构或表面。目前携带治疗性大分子的靶向外泌体通常涉及其生产细胞的基因操作或肽与外泌体表面的化学缀合。
【8】Aging Cell:科学家发现衰老相关的骨髓微环境中外泌体miR-31a-5p调节骨形成和骨吸收
骨髓微环境中细胞衰老相关分子的改变是骨质疏松症的驱动因素之一。这些分子通过调节成骨细胞和破骨细胞活性来抑制骨形成并促进骨吸收,从而导致骨组织老化。来自南京医科大学蒋红兵课题组在Aging Cell杂志发表论文,揭示了miR-31a-5p作为衰老相关的骨髓微环境的重要调节剂,影响成骨细胞和破骨细胞的分化,可能作为与衰老有关的骨质疏松症的潜在治疗靶点。
骨组织老化的特征是骨形成的减少和骨吸收的增加,通常会导致诸如骨质疏松症等疾病。成骨细胞形成骨骼与破骨细胞的骨吸收之间的平衡对维持骨量是重要的。新的证据表明,单核细胞、巨噬细胞、破骨细胞与骨髓基质细胞(BMSCs)成骨细胞之间的相互关系在骨质疏松症的病理学中起着至关重要的作用。随着机体衰老,具有衰老相关表型分泌(SASP)的分子被衰老细胞分泌到骨微环境中。这些分子减弱成骨分化以及促进BMSCs的成脂分化和衰老,这被认为是骨质疏松性骨丢失的主要原因。重要的是,这些SASP成分可能在BMSCs和破骨细胞之间传递信号,从而调节骨重塑的状态。然而,骨髓间充质干细胞功能障碍和BMSCs与破骨细胞间通讯的分子机制还不完全清楚。
【9】mBio:打破认知!HIV关键蛋白竟然可以通过外泌体分泌到细胞外发挥作用!
doi:10.1128/mBio.02344-17
根据北卡罗来纳大学(UNC)莱恩博格综合癌症中心实验室的一项最新研究,HIV也许可以通过将关键蛋白质包装在宿主细胞细胞器中并将之分泌到细胞外来影响HIV不能直接影响的细胞。
研究人员在《mBio》上报道了这项研究,该研究发现HIV可以使用外泌体将病毒蛋白Nef分泌到细胞外。考虑到这个蛋白被分泌到细胞外一定有其作用,研究人员正在计划进一步研究这个蛋白在感染免疫细胞之外的作用。
“这项研究表明一个叫做Nef的HIV蛋白的循环途径与病毒本身并不相同。”UNC医学院微生物学与免疫学系Dirk Dittmer教授说道。“这可以解释为什么HIV可以感染它最初不直接接触的细胞,如血脑屏障中的内皮细胞。”
【10】Nature子刊:外泌体miR-21成为神经性疼痛的治疗靶点
伦敦国王学院的一项新研究揭示了神经病理性疼痛中神经元和免疫细胞之间未曾发现的细胞通讯机制。研究人员发现了一种治疗小鼠神经性疼痛的新方法,与目前含有阿片类药物和抗癫痫药物的治疗相比,这种方法更为安全有效。
神经性疼痛是一种通常由神经损伤引起的慢性疼痛,但在损伤愈合后疼痛持续很久。 神经性疼痛可能发生在手术或车祸后,或在某些情况下肢体被截肢。
目前唯一可用于神经性疼痛的药物是阿片类药物或抗癫痫药物。 阿片类药物,如吗啡和曲马多,成瘾性很高,最近NHS对这些药物的过度用药感到担忧,因为现在阿片类药物用量相比十年前增加了一倍以上。
(本文来源生物谷)
想要了解更多请关注“中洪博元医学实验帮